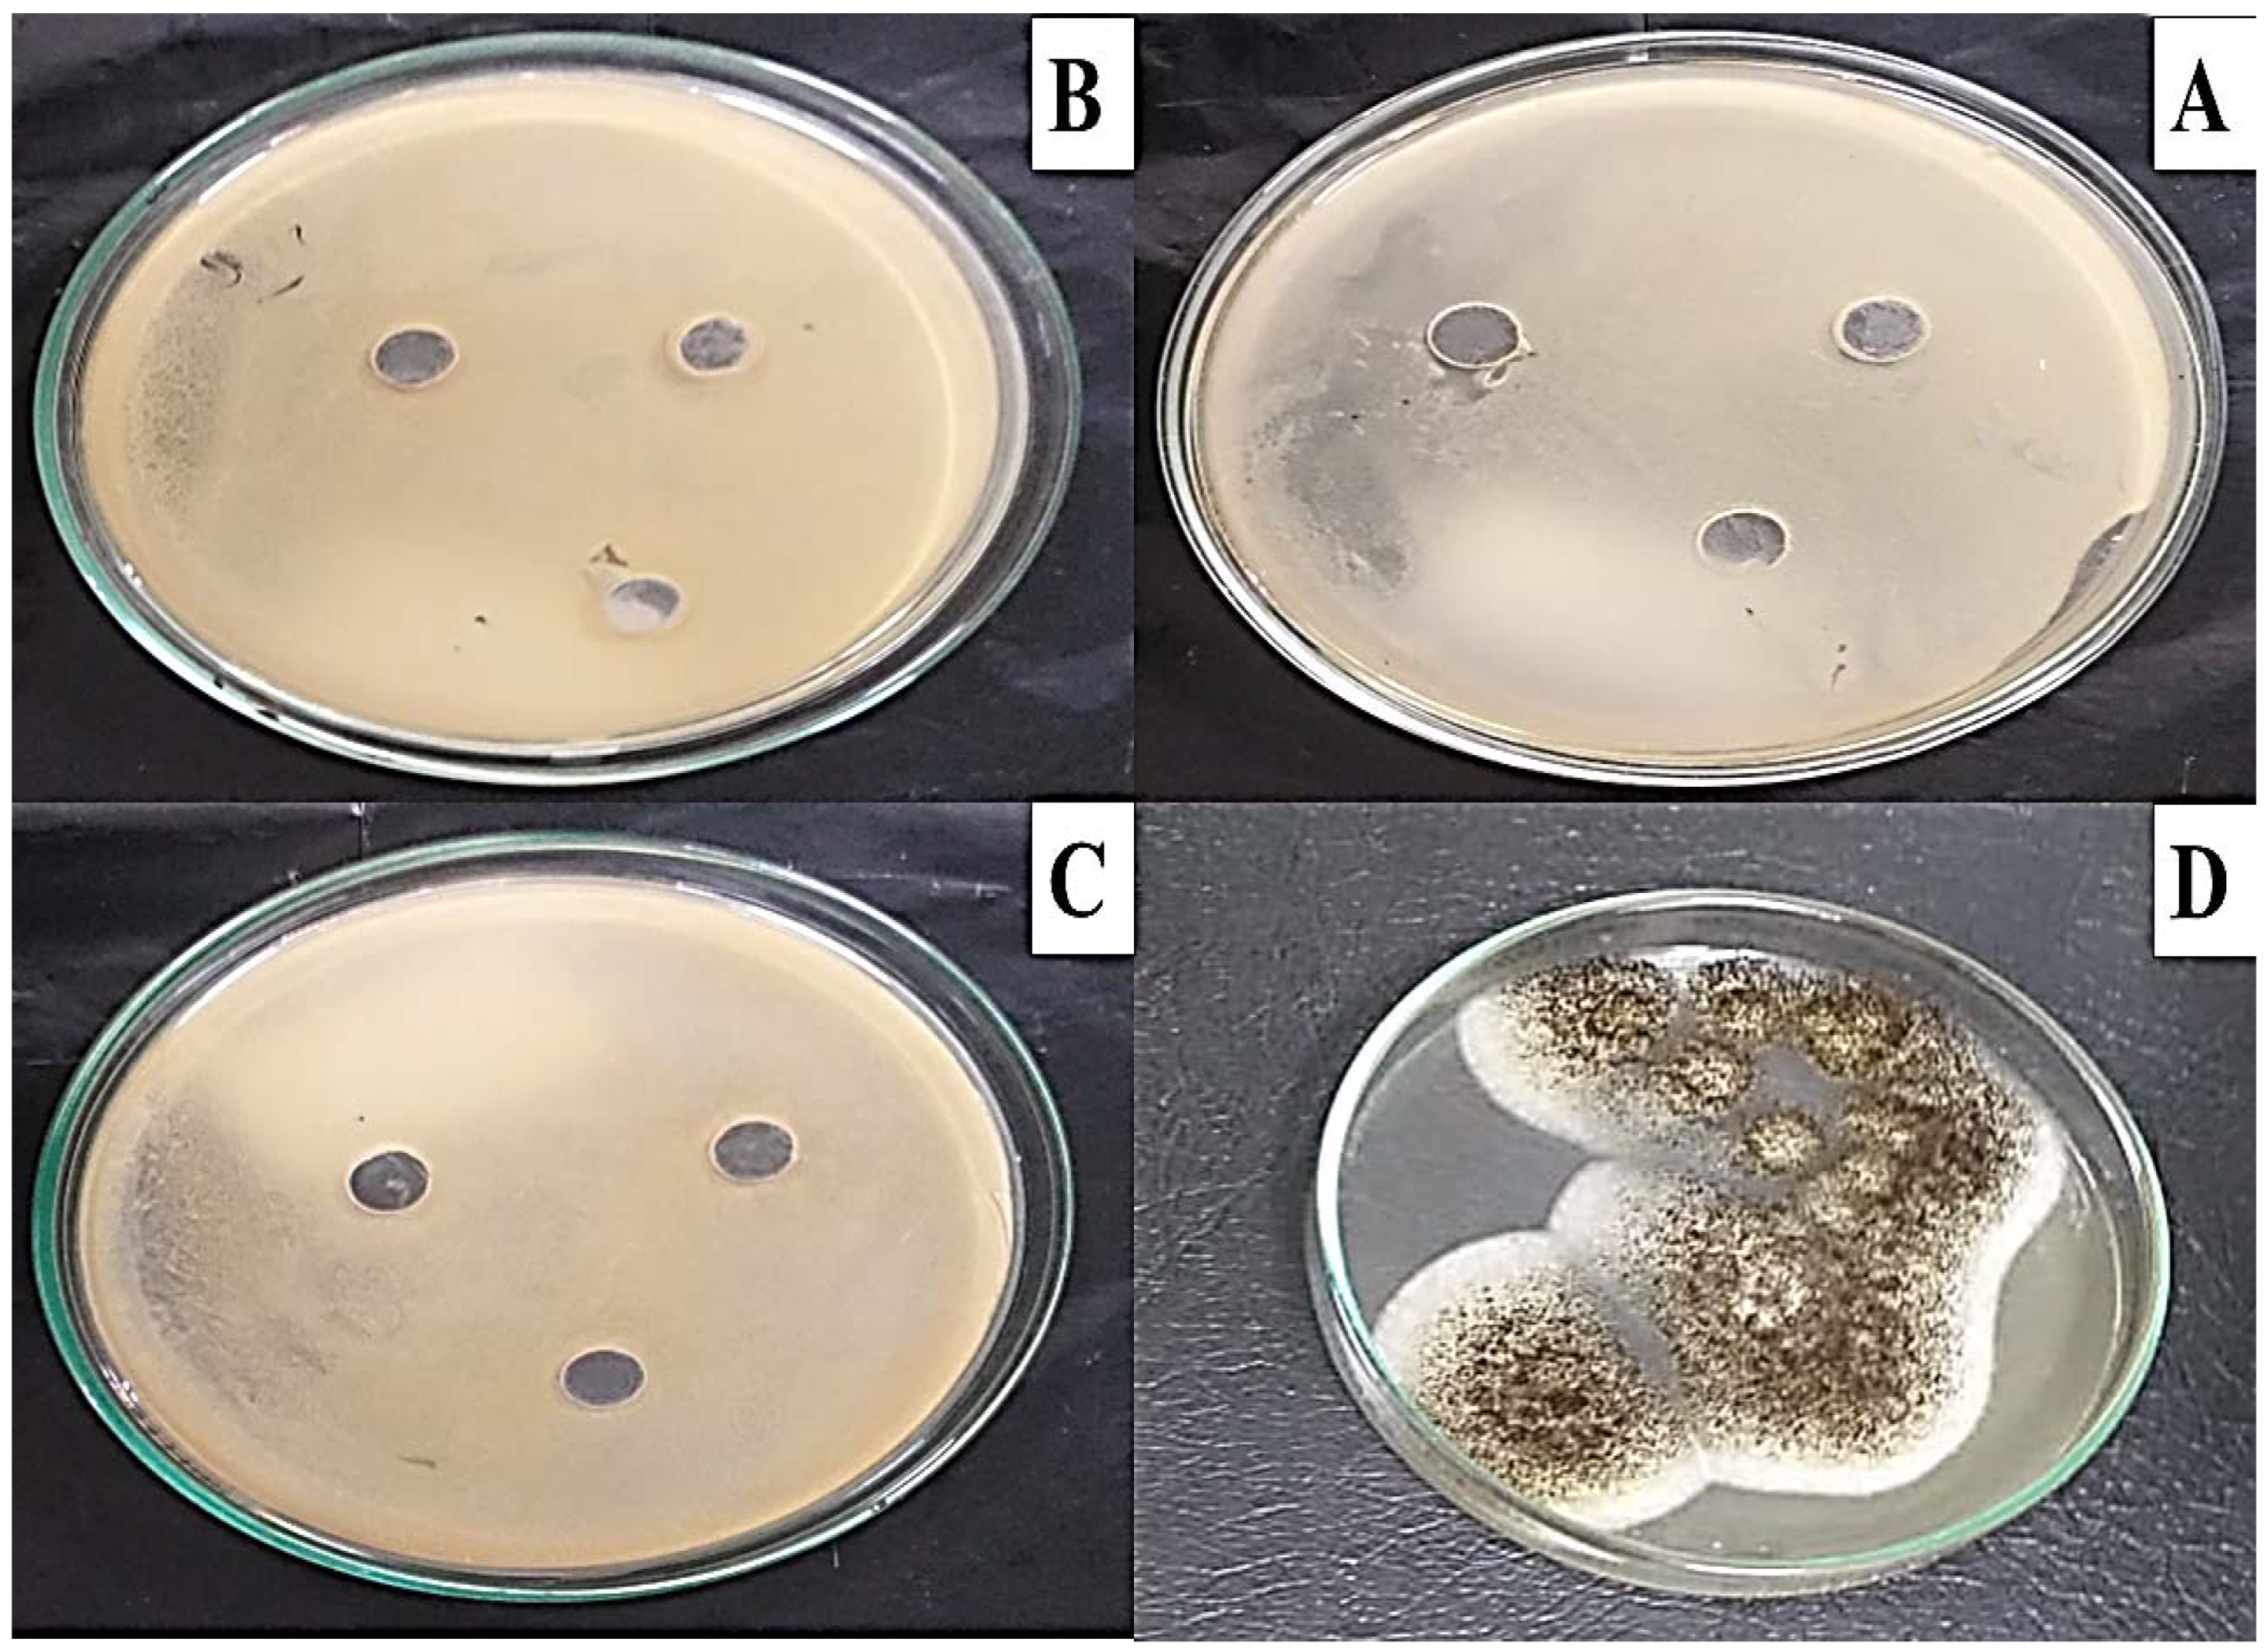
Molecules 27 06456 g009

Microbial Degradation, Spectral analysis and Toxicological Assessment of Malachite Green Dye by Streptomyces exfoliatus
Abstract
1. Introduction
2. Results
2.1. Isolation of MG-Biodegrading Actinomycetes Isolates
2.2. Molecular Identification of Streptomyces St45 Isolates Using 16S rRNA Genetic Sequencing
2.3. Optimization of MG Dye Decolorization Using Statistical Experimental Strategies
2.3.1. Effect of Incubation Time on the Decolorization of MG Dye
2.3.2. Screening of Physical and Nutritional Factors Affecting Dye Removal by S. exfoliatus Using Plackett–Burman Design (PBD)
2.3.3. Optimization of the Most Significant Factors for Dye Decolorization Using Composite Central Design (CCD)
A∗D + 19.2 A∗B − 0.6 E∗C − 0.2 E∗D + 0.05 E∗B − 9.97 C∗D + 3.4 C∗B + 0.3 D∗A − 18282.9 A2 − 0.2 E2 − 18.8 C2
− 1.0 D2 – 0.2 B2.
2.4. Phytotoxicity
2.5. Microbial Toxicity
2.6. Cytotoxicity
2.7. GC-MS Analysis for MG Biodegradation Products
3. Discussion
4. Material and Methods
4.1. Chemicals, Dye, and Microorganisms
4.2. Isolation of Malachite Green-Biodegrading Streptomyces Isolates
4.3. Culture Media
4.4. Standard Inoculum
4.5. Screening for Laccase Enzyme Production
4.6. Genomic Identification of the Selected Isolate Using 16S rRNA Gene Sequencing
4.7. Growth Kinetics of S. exfoliatus
4.8. Statistical Screening of Physical and Nutritional Factors Affecting Dye Removal by A. flavus NRRL3357 Using Plackett–Burman Design (PBD)
4.9. Optimization of the Most Efficient Factors for Dye Decolorization Using Central Composite Design (CCD)
β55E2 + β12AB + β13AC + β14AD + β15AE + β23BC + β24BD + β25BE +
β34CD + β35CE + β45DE
4.10. Phytotoxicity Toxicity of Malachite Green Dye before and after Biodegradtaion
4.10.1. Broccoli (Brassica oleracea var. italic) and Lettuce (Lactuca sativa var. capitata) Seeds
sowed seeds) × 100.
4.10.2. Vicia Fabae Beans
4.11. Microbial Toxicity
4.12. Cytotoxicity
4.13. Identification of the Biodegradation Products of Malachite Green Dye
4.13.1. High-Performance Liquid Chromatography (HPLC)
4.13.2. Gas Chromatography-Mass Spectrometry (GC-MS)
5. Conclusions
Supplementary Materials
Author Contributions
Funding
Institutional Review Board Statement
Informed Consent Statement
Acknowledgments
Conflicts of Interest
References
- Hemdan, B.A.; El-Taweel, G.E.; Goswami, P.; Pant, D.; Sevda, S. The role of biofilm in the development and dissemination of ubiquitous pathogens in drinking water distribution systems: An overview of surveillance, outbreaks, and prevention. World J. Microbiol. Biotechnol. 2021, 37, 36. [Google Scholar] [CrossRef] [PubMed]
- Taoufik, G.; Khouni, I.; Ghrabi, A. Assessment of physico-chemical and microbiological surface water quality using multivariate statistical techniques: A case study of the Wadi El-Bey River, Tunisia. Arab. J. Geosci. 2017, 10, 181. [Google Scholar] [CrossRef]
- Yaseen, D.A.; Scholz, M. Textile Dye Wastewater Characteristics and Constituents of Synthetic Effluents: A Critical Review; Springer: Berlin/Heidelberg, Germany, 2019; Volume 16. [Google Scholar] [CrossRef]
- Fu, L.; You, S.; Zhang, G.; Yang, F.; Fang, X. Degradation of azo dyes using in-situ Fenton reaction incorporated into H2O2 -producing microbial fuel cell. Chem. Eng. J. 2010, 160, 164–169. [Google Scholar] [CrossRef]
- Garcia, V.S.G.; Rosa, J.M.; Borrely, S.I. Toxicity and color reduction of a textile effluent containing reactive red 239 dye by electron beam irradiation. Radiat. Phys. Chem. 2020, 172, 108765. [Google Scholar] [CrossRef]
- Song, J.; Han, G.; Wang, Y.; Jiang, X.; Zhao, D.; Li, M.; Mu, Y. Pathway and kinetics of malachite green biodegradation by Pseudomonas veronii. Sci. Rep. 2020, 10, 4502. [Google Scholar] [CrossRef] [PubMed]
- Jadhav, J.P.; Govindwar, S.P. Biotransformation of malachite green by Saccharomyces cerevisiae MTCC 463. Yeast 2006, 23, 315–323. [Google Scholar] [CrossRef]
- Food and Agriculture Organization of the United Nations & World Health Organization. Evaluation of Certain Veterinary Drug Residues in Food; FAO: Rome, Italy, 2009; pp. 1–134. [Google Scholar]
- Bottoni, P.; Caroli, S. Presence of residues and metabolites of pharmaceuticals in environmental compartments, food commodities and workplaces: A review spanning the three-year period 2014–2016. Microchem. J. 2018, 136, 2–24. [Google Scholar] [CrossRef]
- Rijuta, S.; Ganesh, S.; Shu, C.; Sanjay, G. Bacterial decolorization and degradation of azo dyes: A review. J. Taiwan Inst. Chem. Eng. 2011, 42, 138–157. [Google Scholar]
- Vignesh, A.; Manigundan, K.; Santhoshkumar, J.; Shanmugasundaram, T.; Gopikrishnan, V.; Radhakrishnan, M.; Balagurunathan, R. Microbial degradation, spectral analysis and toxicological assessment of malachite green by Streptomyces chrestomyceticus S20. Bioprocess Biosyst. Eng. 2020, 43, 1457–1468. [Google Scholar] [CrossRef]
- Parthipan, P.; Preetham, E.; Machuca, L.; Rahman, P.; Murugan, K.; Rajasekar, A. Biosurfactant and degradative enzymes mediated crude oil degradation by bacterium Bacillus subtilis A1. Front. Microbiol 2017, 8, 193. [Google Scholar] [CrossRef]
- Polti, M.; Aparicio, J.D.; Benimeli, C.S.; Amoroso, M.J. Simultaneous bioremediation of Cr (VI) and lindane in soil by actinobacteria. Int. Biodeterior. Biodegrad. 2014, 88, 48–55. [Google Scholar] [CrossRef]
- Periasamy, D.; Mani, S.; Ambikapathi, R. White rot fungi and their enzymes for the treatment of industrial dye effluents. In Recent Advancement in White Biotechnology through Fungi; Springer: Cham, Switzerland, 2019; pp. 73–100. [Google Scholar]
- Berardi, G.; Wakabayashi, G.; Igarashi, K.; Ozaki, T.; Toyota, N.; Tsuchiya, A.; Nishikawa, K. Full laparoscopic anatomical segment 8 resection for hepatocellular carcinoma using the Glissonian approach with indocyanine green dye fluorescence. Ann. Surg. Oncol. 2019, 26, 2577–2578. [Google Scholar] [CrossRef]
- Shanmugam, S.; Ulaganathan, P.; Swaminathan, K.; Sadhasivam, S.; Wu, Y.R. Enhanced biodegradation and detoxification of malachite green by Trichoderma asperellum laccase: Degradation pathway and product analysis. Int. Biodeterior. Biodegrad. 2017, 125, 258–268. [Google Scholar] [CrossRef]
- Ali, H.; Ahmad, W.; Haq, T. Decolorization and degradation of malachite green by Aspergillus flavus and Alternaria solani. Afr. J. Biotechnol. 2009, 8, 1574–1576. [Google Scholar]
- Parshetti, G.; Kalme, S.; Saratale, G.; Govindwar, S. Biodegradation of malachite green by Kocuria rosea MTCC 1532. Acta Chim. Slov. 2006, 53, 492–498. [Google Scholar]
- Parshetti, G.K.; Kalme, S.D.; Gomare, S.S.; Govindwar, S.P. Biodegradation of Reactive blue-25 by Aspergillus ochraceus NCIM-1146. Bioresour. Technol. 2007, 98, 3638–3642. [Google Scholar] [CrossRef]
- Knapp, J.S.; Newby, P.S.; Reece, L.P. Decolorization of dyes by wood-rotting basidiomycete fungi. Enzym. Microb. Technol. 1995, 17, 664–668. [Google Scholar] [CrossRef]
- Revankar, M.S.; Lele, S.S. Synthetic dye decolorization by white rot fungus, Ganoderma sp. WR-1. Bioresour. Technol. 2007, 98, 775–780. [Google Scholar] [CrossRef]
- Lacina, C.; Germain, G.; Spiros, A.N. Utilization of fungi for biotreatment of raw wastewaters. Afr. J. Biotechnol. 2003, 2, 620–630. [Google Scholar]
- Pearce, C.I.; Lloyd, J.R.; Guthrie, J.T. The removal of colour from textile wastewater using whole bacterial cells: A review. Dye. Pigment. 2003, 58, 179–196. [Google Scholar] [CrossRef]
- Sun, J.; Hu, Y.Y.; Bi, Z.; Cao, Y.Q. Simultaneous decolorization of azo dye and bioelectricity generation using a microfiltration membrane air-cathode single-chamber microbial fuel cell. Bioresour. Technol. 2009, 100, 3185–3192. [Google Scholar] [CrossRef] [PubMed]
- Sumathi, S.; Manju, B.S. Uptake of reactive textile dyes by Aspergillus foetidus. Enzym. Microb. Technol. 2000, 27, 347–355. [Google Scholar] [CrossRef]
- Mu, Y.; Rabaey, K.; Rozendal, R.; Yuan, Z.; Keller, J. Decolorization of azo dyes in bioelectrochemical systems. Environ. Sci. Technol. 2009, 43, 5137–5143. [Google Scholar] [CrossRef] [PubMed]
- Pradnya, A.; Joshi, K.; Mhatre, J. Microbial efficiency to degrade Carbol fuchsin and Malachite green dyes. Adv. Appl. Sci. Res. 2015, 6, 85–88. [Google Scholar]
- Alshehrei, F. Optimization of malachite green and crystal violet decolorization by Bacillus cereus and Pseudomonas earoginosa. Ann. Biol. Res. 2018, 9, 1–8. [Google Scholar]
- Kapanen, A.; Itavaara, M. Ecotoxicity tests for compost applications. Ecotoxicol. Environ. Saf. 2001, 49, 1–16. [Google Scholar] [CrossRef]
- Sneha, U.; Poornima, R.; Sridhar, S. Optimization and decolorization of malachite green using Pseudomonas putida. J. Chem. Pharm. Res. 2014, 6, 50–57. [Google Scholar]
- Bhavsar, S.; Dudhagara, P.; Tank, S. R software package based statistical optimization of process components to simultaneously enhance the bacterial growth, laccase production and textile dye decolorization with cytotoxicity study. PLoS ONE 2018, 13, e0195795. [Google Scholar] [CrossRef]
- Sushama, S.G.; Ganesh, K.P.; Sanjay, P.G. Biodegradation of Malachite Green by Brevibacillus laterosporus MTCC 2298. Water Environ. Res. 2009, 81, 2329–2336. [Google Scholar]
- Chen, C.Y.; Kuo, J.T.; Cheng, C.Y.; Huang, Y.T.; Ho, I.H.; Chung, Y.C. Biological decolorization of dye solution containing malachite green by Pandoraea pulmonicola YC32 using a batch and continuous system. J. Hazard. Mater. 2009, 172, 1439–1445. [Google Scholar] [CrossRef]
- Chen, C.H.; Chang, C.F.; Liu, S.M. Partial degradation mechanisms of malachite green and methyl violet B by Shewanella decolorationis NTOU1 under anaerobic conditions. J. Hazard. Mater. 2010, 177, 281–289. [Google Scholar] [CrossRef]
- Li, L.T.; Hong, Q.; Yan, X.; Fang, G.H.; Ali, S.W.; Li, S.P. Isolation of a malachite green-degrading Pseudomonas sp. MDB-1 strain and cloning of the tmr2 gene. Biodegradation 2009, 20, 769–776. [Google Scholar] [CrossRef]
- Du, L.; Wang, S.; Li, G.; Wang, B.; jia, X.; Zhao, Y.; Chen, Y. Biodegradation of malachite green by Pseudomonas sp. strain DY1 under aerobic condition: Characteristics, degradation products, enzyme analysis and phytotoxicity. Ecotoxicology 2011, 20, 438–446. [Google Scholar] [CrossRef]
- Culp, S.J.; Beland, F.A. Malachite Green: A Toxicological Review. J. Am. Coll. Toxicol. 1996, 15, 219–238. [Google Scholar] [CrossRef]
- Araújo, A.S.; Monteiro, R.T. Plant bioassays to assess toxicity of textile sludge compost. Sci. Agric. 2005, 62, 286–290. [Google Scholar] [CrossRef]
- Vogel, H.J. A convenient growth medium for Neurospora (Medium N). Microbiol. Genet. Bull. 1956, 13, 42–43. [Google Scholar]
- Coll, P.M.; Abalos, J.M.F.; Villanueva, J.R.; Santamaria, R.; Perez, P. Purification and characterization of Phenoloxidase (Laccase) from the Lignin-Degrading Basidiomycete PM1(CECT 2971). Appl. Environ. Microbiol. 1993, 59, 2607–2613. [Google Scholar] [CrossRef]
- Al-Dhabi, N.A.; Esmail, G.A.; Duraipandiyan, V.; Valan Arasu, M.; Salem-Bekhit, M.M. Isolation, identification and screening of antimicrobial thermophilic Streptomyces sp. Al-Dhabi-1 isolated from Tharban hot spring, Saudi Arabia. Extremophiles 2016, 20, 79–90. [Google Scholar] [CrossRef]
- Felsenstein, J. Confidence limits on phylogenies: An approach using the bootstrap. Evolution 1985, 39, 783–791. [Google Scholar] [CrossRef]
- Tamura, K.; Stecher, G.; Peterson, D.; Filipski, A.; Kumar, S. MEGA6: Molecular evolutionary genetics analysis version 6.0. Mol. Biol. Evol. 2013, 28, 2731–2739. [Google Scholar] [CrossRef]
- Casieri, L.; Varese, G.C.; Anastasi, A.; Prigione, V.; Svobodová, K.; Filippelo Marchisio, V.; Novotný, Č. Decolorization and detoxication of reactive industrial dyes by immobilized fungi Trametes pubescens and Pleurotus ostreatus. Folia Microbiol. 2008, 53, 44–52. [Google Scholar] [CrossRef] [PubMed]
- Asses, N.; Ayed, L.; Hkiri, N.; Hamdi, M. Congo Red Decolorization and Detoxification by Aspergillus niger: Removal Mechanisms and Dye Degradation Pathway. BioMed Res. Int. 2018, 2018, 3049686. [Google Scholar] [CrossRef] [PubMed]
- Clinical and Laboratory Standards Institute. Performance Standards for Antimicrobial Susceptibility Testing; Twenty-Fifth Informational Supplement, 27th ed.; CLSI Document M100-S25; Clinical and Laboratory Standards Institute—CLSI: Wayne, PA, USA, 2017. [Google Scholar]
- Skehan, P.; Storeng, R.; Scudiero, D.; Monks, A.; McMahon, J.; Vistica, D.; Warren, J.T.; Bokesch, H.; Kenney, S.; Boyd, M.R. New colorimetric cytotoxicity assay for anticancer-drug screening. J. Natl. Cancer Inst. 1990, 82, 1107–1112. [Google Scholar] [CrossRef] [PubMed]
- Wang, J.; Gao, F.; Liu, Z.; Qiao, M.; Niu, X.; Zhang, K.; Huang, X. Pathway and Molecular Mechanisms for Malachite Green Biodegradation in Exiguobacterium sp. MG2. PLoS ONE 2012, 7, e51808. [Google Scholar] [CrossRef]
- Mamoun, S.M.A.; Mohamed, A.R.; Ezzat, T.M.S.; Elsherbiny, A.E.; Ayman, Y.E. Application of GC/EIMS in Combination with Semi-Empirical Calculations for Identification and Investigation of Some Volatile Components in Basil Essential Oil. Int. J. Anal. Mass Spectrom. Chromatogr. 2016, 4, 14–25. [Google Scholar] [CrossRef]

| Runs | Levels | Variables | Decolorization % | ||||
| A | B | C | D | E | |||
| Low | 0.03 | 10.0 | 0.20 | 6.0 | 5.0 | ||
| Mid | 0.04 | 12.5 | 0.35 | 7.0 | 7.5 | ||
| High | 0.05 | 15.0 | 0.50 | 8.0 | 10.0 | ||
| 1 | 0.04 | 12.5 | 0.35 | 7.0 | 7.5 | 97.56 | |
| 2 | 0.03 | 10.0 | 0.20 | 6.0 | 10.0 | 82.73 | |
| 3 | 0.04 | 12.5 | 0.35 | 8.0 | 7.5 | 98.10 | |
| 4 | 0.04 | 12.5 | 0.35 | 5.0 | 7.5 | 91.26 | |
| 5 | 0.05 | 10.0 | 0.20 | 6.0 | 5.0 | 93.29 | |
| 6 | 0.04 | 12.5 | 0.65 | 7.0 | 7.5 | 93.76 | |
| 7 | 0.03 | 15.0 | 0.20 | 6.0 | 5.0 | 90.71 | |
| 8 | 0.05 | 15.0 | 0.50 | 8.0 | 10.0 | 94.96 | |
| 9 | 0.04 | 12.5 | 0.35 | 7.0 | 7.5 | 95.97 | |
| 10 | 0.04 | 12.5 | 0.35 | 7.0 | 7.5 | 95.97 | |
| 11 | 0.05 | 15.0 | 0.20 | 6.0 | 10.0 | 91.54 | |
| 12 | 0.03 | 10.0 | 0.50 | 8.0 | 10.0 | 93.99 | |
| 13 | 0.04 | 17.5 | 0.35 | 7.0 | 7.5 | 94.37 | |
| 14 | 0.05 | 10.0 | 0.50 | 6.0 | 10.0 | 93.61 | |
| 15 | 0.04 | 7.5 | 0.35 | 7.0 | 7.5 | 95.06 | |
| 16 | 0.04 | 12.5 | 0.35 | 7.0 | 7.5 | 97.72 | |
| 17 | 0.04 | 12.5 | 0.35 | 7.0 | 2.5 | 95.97 | |
| 18 | 0.04 | 12.5 | 0.35 | 7.0 | 7.5 | 95.44 | |
| 19 | 0.02 | 12.5 | 0.35 | 7.0 | 7.5 | 86.06 | |
| 20 | 0.03 | 15.0 | 0.50 | 6.0 | 10.0 | 91.55 | |
| 21 | 0.05 | 15.0 | 0.50 | 6.0 | 5.0 | 93.29 | |
| 22 | 0.03 | 15.0 | 0.50 | 6.0 | 5.0 | 94.18 | |
| 23 | 0.05 | 15.0 | 0.20 | 8.0 | 5.0 | 97.16 | |
| 24 | 0.05 | 10.0 | 0.50 | 8.0 | 5.0 | 92.58 | |
| 25 | 0.03 | 10.0 | 0.50 | 6.0 | 5.0 | 89.86 | |
| 26 | 0.03 | 15.0 | 0.20 | 8.0 | 10.0 | 96.43 | |
| 27 | 0.04 | 12.5 | 0.35 | 9.0 | 7.5 | 93.16 | |
| 28 | 0.04 | 12.5 | 0.05 | 7.0 | 7.5 | 95.21 | |
| 29 | 0.06 | 12.5 | 0.35 | 7.0 | 7.5 | 92.28 | |
| 30 | 0.03 | 10.0 | 0.20 | 8.0 | 5.0 | 96.62 | |
| 31 | 0.04 | 12.5 | 0.35 | 7.0 | 12.5 | 93.31 | |
| 32 | 0.05 | 10.0 | 0.20 | 8.0 | 10.0 | 96.83 | |
| Analysis of variance (ANOVA) | |||||||
| Model | |||||||
| F-value | 5.00 | 12.13 | 1.10 | 0.24 | 22.08 | 1.79 | |
| p-value | 0.004 * | 0.005 * | 0.316 | 0.632 | 0.001 * | 0.208 | |
| R2 | 0.9 | ||||||
| Std. Dev. | 1.74 | ||||||
| Runs | Levels | Variables | Decolorization % | ||||||||||
| A | B | C | D | E | F | G | H | J | K | L | |||
| Low | 0 | 0 | 0.1 | 1 | 1 | 6 | 0 | 25 | 5 | 96 | 0.05 | ||
| High | 5 | 5 | 0.2 | 5 | 5 | 8 | 150 | 35 | 10 | 120 | 0.50 | ||
| 1 | 5.0 | 5.0 | 0.10 | 5 | 5 | 8 | 0 | 25 | 5.0 | 120 | 0.05 | 25.38 | |
| 2 | 5.0 | 0.0 | 0.10 | 1 | 5 | 6 | 150 | 35 | 5.0 | 120 | 0.50 | 12.89 | |
| 3 | 2.5 | 2.5 | 0.15 | 3 | 3 | 7 | 75 | 30 | 7.5 | 72 | 0.27 | 24.75 | |
| 4 | 2.5 | 2.5 | 0.15 | 3 | 3 | 7 | 75 | 30 | 7.5 | 72 | 0.27 | 24.89 | |
| 5 | 0.0 | 0.0 | 0.10 | 1 | 1 | 6 | 0 | 25 | 5.0 | 96 | 0.05 | 26.34 | |
| 6 | 0.0 | 0.0 | 0.10 | 5 | 1 | 8 | 0 | 35 | 10.0 | 120 | 0.50 | 7.77 | |
| 7 | 2.5 | 2.5 | 0.15 | 3 | 3 | 7 | 75 | 30 | 7.5 | 72 | 0.27 | 21.94 | |
| 8 | 0.0 | 5.0 | 0.10 | 5 | 5 | 6 | 150 | 35 | 10.0 | 96 | 0.05 | 51.77 | |
| 9 | 2.5 | 2.5 | 0.15 | 3 | 3 | 7 | 75 | 30 | 7.5 | 72 | 0.27 | 23.88 | |
| 10 | 5.0 | 0.0 | 0.20 | 5 | 1 | 8 | 150 | 35 | 5.0 | 96 | 0.05 | 38.10 | |
| 11 | 0.0 | 5.0 | 0.20 | 1 | 5 | 8 | 0 | 35 | 5.0 | 96 | 0.50 | 5.34 | |
| 12 | 2.5 | 2.5 | 0.15 | 3 | 3 | 7 | 75 | 30 | 7.5 | 72 | 0.27 | 26.83 | |
| 13 | 0.0 | 0.0 | 0.20 | 1 | 5 | 8 | 150 | 25 | 10.0 | 120 | 0.05 | 54.49 | |
| 14 | 5.0 | 5.0 | 0.10 | 1 | 1 | 8 | 150 | 25 | 10.0 | 96 | 0.50 | 22.32 | |
| 15 | 0.0 | 5.0 | 0.20 | 5 | 1 | 6 | 150 | 25 | 5.0 | 120 | 0.50 | 24.78 | |
| 16 | 2.5 | 2.5 | 0.15 | 3 | 3 | 7 | 75 | 30 | 7.5 | 72 | 0.27 | 29.86 | |
| 17 | 5.0 | 0.0 | 0.20 | 5 | 5 | 6 | 0 | 25 | 10.0 | 96 | 0.50 | 20.12 | |
| 18 | 5.0 | 5.0 | 0.20 | 1 | 1 | 6 | 0 | 35 | 10.0 | 120 | 0.05 | 81.11 | |
| Analysis of variance (ANOVA) | |||||||||||||
| Model | |||||||||||||
| F-value | 18.17 | 2.47 | 7.42 | 17.12 | 3.41 | 2.64 | 11.54 | 4.18 | 1.75 | 31.3 | 5.14 | 96.54 | |
| p-value | 0.0004 | 0.160 | 0.030 * | 0.004 * | 0.107 | 0.148 | 0.012 * | 0.080 | 0.234 | 0.001 * | 0.058 | <0.0001 * | |
| Main effect | 4.90 | 8.50 | 12.91 | −5.76 | −5.07 | −10.6 | 3.93 | 6.38 | 17.46 | 7.07 | −30.66 | ||
| R2 | 0.96 | ||||||||||||
| Std. Dev. | 5.41 | ||||||||||||
Publisher’s Note: MDPI stays neutral with regard to jurisdictional claims in published maps and institutional affiliations. |
© 2022 by the authors. Licensee MDPI, Basel, Switzerland. This article is an open access article distributed under the terms and conditions of the Creative Commons Attribution (CC BY) license (https://creativecommons.org/licenses/by/4.0/).
Share and Cite
Abu-Hussien, S.H.; Hemdan, B.A.; Alzahrani, O.M.; Alswat, A.S.; Alatawi, F.A.; Alenezi, M.A.; Darwish, D.B.E.; Bafhaid, H.S.; Mahmoud, S.F.; Ibrahim, M.F.M.; et al. Microbial Degradation, Spectral analysis and Toxicological Assessment of Malachite Green Dye by Streptomyces exfoliatus. Molecules 2022, 27, 6456. https://doi.org/10.3390/molecules27196456
Abu-Hussien SH, Hemdan BA, Alzahrani OM, Alswat AS, Alatawi FA, Alenezi MA, Darwish DBE, Bafhaid HS, Mahmoud SF, Ibrahim MFM, et al. Microbial Degradation, Spectral analysis and Toxicological Assessment of Malachite Green Dye by Streptomyces exfoliatus. Molecules. 2022; 27(19):6456. https://doi.org/10.3390/molecules27196456
Chicago/Turabian StyleAbu-Hussien, Samah H., Bahaa A. Hemdan, Othman M. Alzahrani, Amal S. Alswat, Fuad A. Alatawi, Muneefah Abdullah Alenezi, Doaa Bahaa Eldin Darwish, Hanouf S. Bafhaid, Samy F. Mahmoud, Mohamed F. M. Ibrahim, and et al. 2022. "Microbial Degradation, Spectral analysis and Toxicological Assessment of Malachite Green Dye by Streptomyces exfoliatus" Molecules 27, no. 19: 6456. https://doi.org/10.3390/molecules27196456
APA StyleAbu-Hussien, S. H., Hemdan, B. A., Alzahrani, O. M., Alswat, A. S., Alatawi, F. A., Alenezi, M. A., Darwish, D. B. E., Bafhaid, H. S., Mahmoud, S. F., Ibrahim, M. F. M., & El-Sayed, S. M. (2022). Microbial Degradation, Spectral analysis and Toxicological Assessment of Malachite Green Dye by Streptomyces exfoliatus. Molecules, 27(19), 6456. https://doi.org/10.3390/molecules27196456

